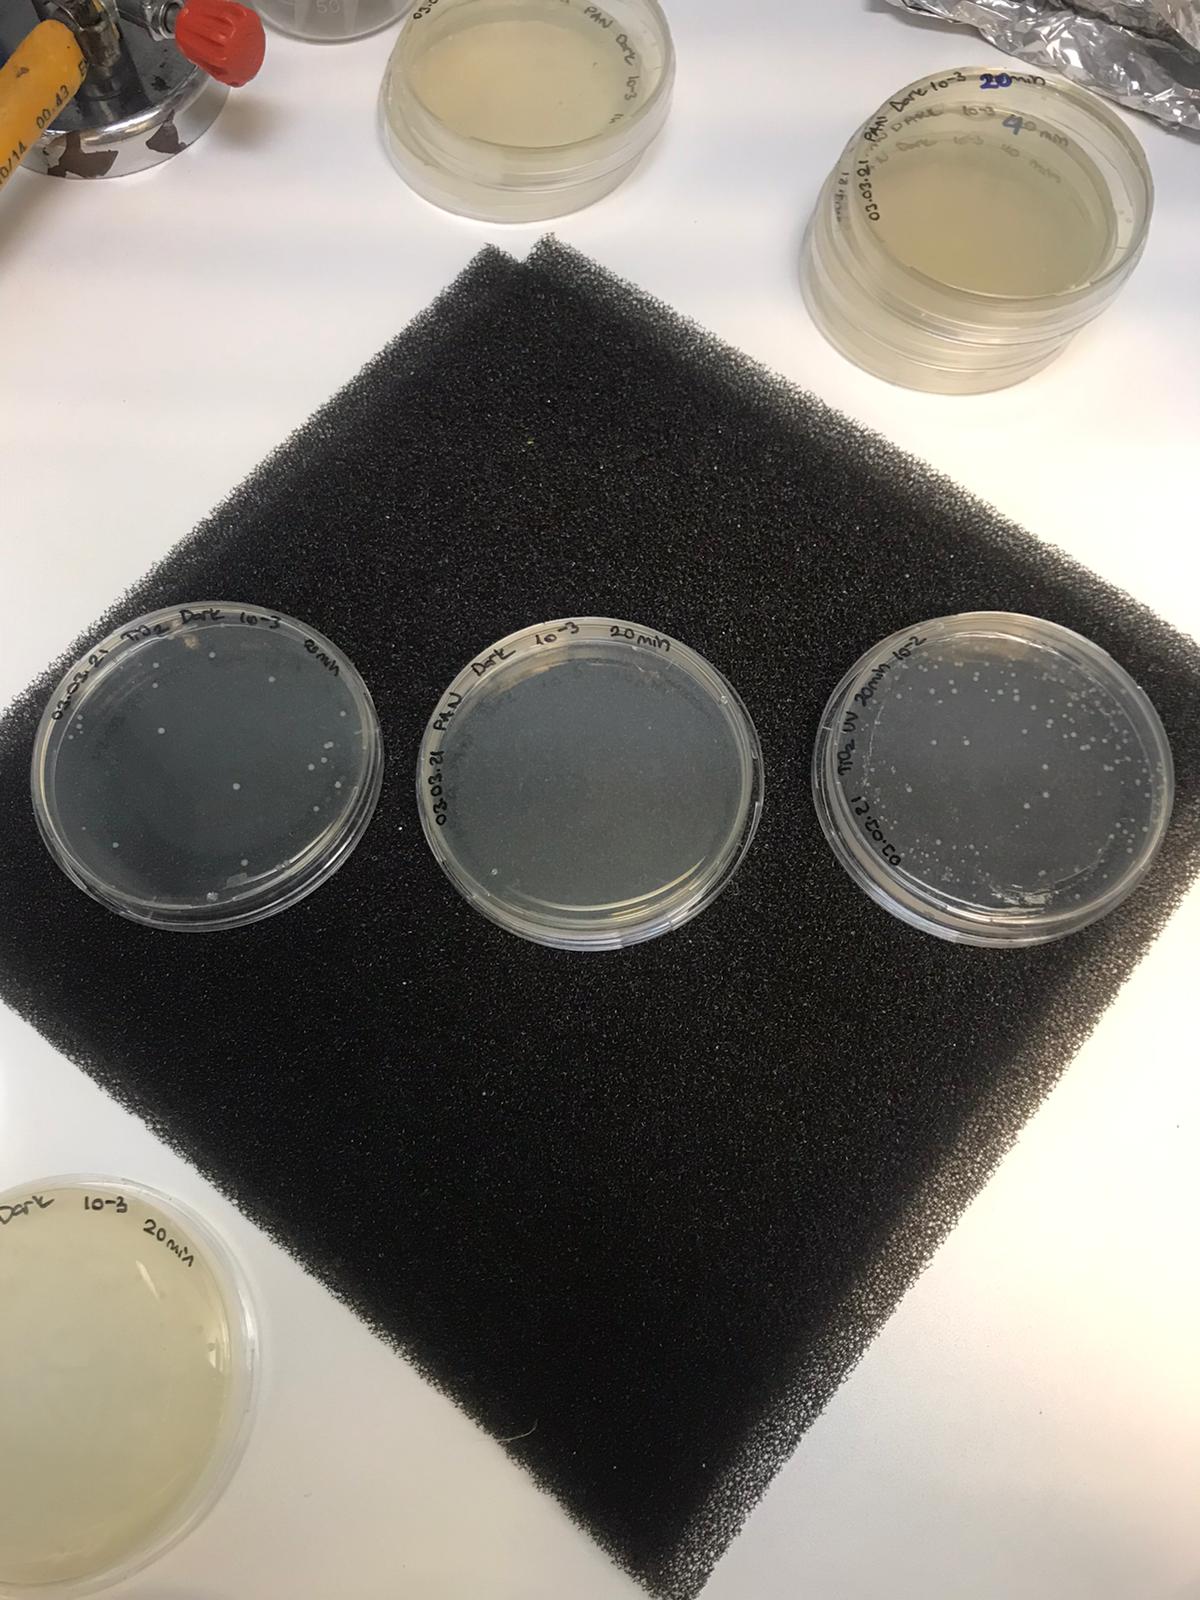
Antimicrobial Tests

Development of antimicrobial nanofiber air filters for bioaerosol removal from indoor air (Filter-based air cleaning technology-FACT)
Indoor air quality plays a very important role in human health. Airborne microorganisms or bioaerosols pose a challenge in terms of indoor air quality (IAQ) protection in residential areas and transport (aircraft and public transport). IAQ can be improved by using high-efficiency filters in engineered systems. Exposure to bioaerosols increases indoor air-related health problems such as infections, allergies and asthma. In particular, these cause additional concerns and risks in early life. Bioaerosol can refer to aerosolized cells, viruses, spores, or biological cellular debris. Bioaerosol filters remain one of the least understood applications of air filtration in terms of the relationships between mechanism of action and filter performance. This project addresses two interrelated aspects of antibacterial air filter development necessary for sustainable filtration performance: antibacterial material fabrication and filter modeling. Two methods are used in the fabrication of antibacterial filters (i) graphene oxide (GO) and enzyme additives (ii) biocidal monomers. This project includes research methodology, fabrication, characterization, validation and testing activities in collaboration between Turkey and the UK. The main objectives of the project are (1) to coordinate the efforts of three academic institutions (Istanbul Technical University, Piri Reis University and Northumbria University) and one SME (Inovenso company) to develop and transfer new knowledge and skills, (2) to apply nanofiber technologies and embed new materials to explore the feasibility of antibacterial air filters, including antimicrobial testing, and (3) to create a new air filter product to improve human health.
Financial Supporter:
TUBITAK1071-Royal Academy Institutional Links Grants
The Duration of the Project:
01/10/2020-01/04/2022
Project Coordinator:
Assoc. Prof. Dr. Derya Yuksel Imer (ITU) and Assoc. Prof. Dr. Matt Unthank (Northumbria University at Newcastle)
Researchers & Collaborators:
Assoc. Prof. Dr. C.Elif Ozen-Cansoy (Piri Reis University-PRU)
Prof David Pearce (Northumbria University Newcastle)
Yusuf Keskin (Inovenso Technology)
Gulbahar Saat (Inovenso Technology)
Dr. Tulay Ergon-Can (PDRA)
Scholars:
Ayse Guventurk (PhD student)
Project Consultant:
Prof. Dr. Kadir Alp (ITU)